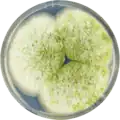
Aspergillus parasiticus growing on CYA plate

Aspergillus parasiticus
| Aspergillus parasiticus | |
|---|---|

| |
| Scientific classification | |
| Kingdom: | Fungi |
| Division: | Ascomycota |
| Class: | Eurotiomycetes |
| Order: | Eurotiales |
| Family: | Aspergillaceae |
| Genus: | Aspergillus |
| Species: | A. parasiticus
|
| Binomial name | |
| Aspergillus parasiticus Speare (1912)
| |
| Type strain | |
| UAMH 9603 | |
| Synonyms | |
| |
Aspergillus parasiticus is a fungus belonging to the genus Aspergillus.[1] This species is an unspecialized saprophytic mold, mostly found outdoors in areas of rich soil with decaying plant material as well as in dry grain storage facilities.[2] Often confused with the closely related species, A. flavus, A. parasiticus has defined morphological and molecular differences.[3] Aspergillus parasiticus is one of three fungi able to produce the mycotoxin, aflatoxin, one of the most carcinogenic naturally occurring substances.[3] Environmental stress can upregulate aflatoxin production by the fungus, which can occur when the fungus is growing on plants that become damaged due to exposure to poor weather conditions, during drought, by insects, or by birds.[2] In humans, exposure to A. parasiticus toxins can cause delayed development in children and produce serious liver diseases and/or hepatic carcinoma in adults.[3] The fungus can also cause the infection known as aspergillosis in humans and other animals. A. parasiticus is of agricultural importance due to its ability to cause disease in corn, peanut, and cottonseed.[2][4]
History and taxonomy
Aspergillus parasiticus was first discovered in 1912 by pathopathologist, A.T Speare from dead mealy bugs collected on Hawaiian sugarcane plantations.[4] The species epithet, "parasiticus" is derived from the Latin word meaning "parasite" and was selected due to the ability of the fungus to parasitize other organisms.[5] The fungus was originally classified as a subspecies of A. flavus called Aspergillus flavus subsp. parasiticus (Speare) due to its strong resemblance to A. flavus. Indeed, this fungus is very closely related to A. flavus[3] and is often misidentified as the latter.[3] However, the two species are separable based on morphological features.[3] A. parasiticus also exhibits physiological differences from A. flavus such as the inability to produce cyclopiazonic acid and the production of aflatoxin G.[6]
Growth and morphology


The conidia of A. parasiticus have rough, thick walls, are spherical in shape, have short conidiophores (~400 μm)[5] with small vesicles averaging 30 μm in size to which the phialides are directly attached.[3] A. parasiticus is further distinguished by its dark green colony colour.[2][1][7] Aspergillus parasiticus colonies are dark green. The average growth temperature for this fungus ranges between 12 and 42 °C with the optimum temperature for growth is at 32 °C and no growth reported at 5 °C.[3] Growth pH ranges from 2.4 to 10.5 with the optimum growth ranging between 3.5–8.[3] For the best growth of the fungus the carbon and nitrogen content in the soil is 1:1 and the pH 5.5.[8] A. parasiticus normally reproduces asexually[2] however, the presence of single mating genes MAT1-1 or MAT1-2 in different strains of the fungus suggests it has a heterothallic mating system and may have a hitherto unrecognized teleomorph.[2][4][7] A. parasiticus grows on cereal agar, Czapek agar, malt extract agar, malt salt agar, and potato dextrose agar. The sclerotia and stromata transform from white to pink, dark brown and black.[2] When grown on "Aspergillus flavus and parasiticus" agar (AFPA), colonies show an orange yellow reverse colouration.[3][9] The conidia are pink when grown on media containing anisaldehyde.[5]
A. parasiticus has been cultivated on both Czapek yeast extract agar (CYA) plates and Malt Extract Agar Oxoid (MEAOX) plates. The growth morphology of the colonies can be seen in the pictures below.
-
Aspergillus parasiticus growing on CYA plate
Aspergillus parasiticus growing on CYA plate -
 Aspergillus parasiticus growing on MEAOX plate
Aspergillus parasiticus growing on MEAOX plate
Physiology
A. parasiticus produces aflatoxins B1, B2, G1, and G2, named for the colours emitted under UV light on thin-layer chromatography plates—either blue and green. The numbers refer to the type of compound with 1 being major and 2 being minor.[3] These aflatoxins are carcinogenic mycotoxins which have detrimental effects to humans and livestock.[4] A. parasiticus also has the ability to produce kojic acid, aspergillic acid, nitropropionic acid and aspertoxin[1] as secondary antimicrobial metabolites in response to different environments, all of which can be useful in identification.[10] A. parasiticus also differs in sclerotia quantity number, volume, and shape.[11] This fungus can be reliably identified using molecular methods.[3]
A. parasiticus produces aflatoxins at higher concentrations than A. flavus in temperatures ranging from 12–42 °C (54–108 °F) with pH ranging from 3 to greater than 8.[3] Light exposure, oxidative growth conditions, fungal volatiles and nutrient availability (sugars and zinc) affect the production of these toxins. Greater zinc availability increases aflatoxin output.[12] Environmental stress caused by drought and/or high temperatures during the latter part of the growing season of crops increases the likelihood of fungal growth.[13] The aflatoxins produced by A. parasiticus are hazardous under normal food handling conditions and are especially stable when absorbed by starch or protein on the surfaces of seeds.[5]
Signs and symptoms
Often, food illnesses are not attributed to A. parasiticus because it is mistaken for A. flavus.[3] Serious symptoms of aflatoxin exposure by either ingestion or inhalation of spores, or through direct skin contact, can occur amongst humans and animals. Signs and symptoms of exposure in humans may include delayed development and stunted growth among children, while adults may experience teratogenic effects,[3] lung damage, ulcers, skin irritation, fever, and acute liver disease, which can later lead to liver carcinoma and death.[2]
Control and management
Most countries put low limits on how much aflatoxin is allowed to be in food.[3] This fungus has low resistance to heat,[3] so in order to reduce [aflatoxin] levels and its toxic effects, foods such as peanuts, hazelnuts, walnuts, pistachios, and pecans[3] can be roasted, can be treated with an alkali such as ammonia, or the crops can be given a microbial treatment.[2] The growth of this fungus can be prevented by proper water management and dust reduction.[2] Corn contaminated by A. parasiticus can be pasteurized by exposure to radio frequency (although any mycotoxins produced in situ will remain intact).[14] Exposure of the fungus to phenolic compounds destabilizes the cellular lipoprotein membrane by increasing hydrophobicity, resulting in a lengthened lag phase, reduction of growth rate and diminished aflatoxin production.[15] Similarly, exposure to phytochemicals such as ascorbic acid, gallic acid, caffeine, and quercetin reduces the growth rate of A. parasiticus.[16]
Habitat and ecology
Aspergillus parasiticus can be found outdoors commonly within an agricultural setting of soil on fields and through the improper handling, drying, transportation and storage of grains and fresh produce.[2][17] This fungus is also commonly found on the stems and roots of peanuts and other plants.[18]
A. parasiticus is a tropical and subtropical species found in the United States, Latin America, South Africa, India and Australia. This species has rarely been reported from Southeast Asia and cool temperate zones.[3]
Fungal spores can be distributed with the wind as well as through moist soil via contact with nuts and kernels, and can survive over the winter months on plant material on the soil.[2]
References
- ^ a b c Kozakiewicz, Z. "Aspergillus parasiticus". CAB International Wallingford UK. doi:10.1079/DFB/20056400994.
{{cite journal}}: Cite journal requires|journal=(help) - ^ a b c d e f g h i j k l Sobel, Lanette. "Aspergillus parasiticus". Bugwood Wiki. Retrieved 21 November 2017.
- ^ a b c d e f g h i j k l m n o p q r s Pitt, J.I.; Hocking, A.D. (1999). Fungi and food spoilage (2nd ed.). Gaithersburg, Md.: Aspen Publications. ISBN 978-0834213067.
- ^ a b c d Horn, Bruce W.; Ramirez-Prado, Jorge H.; Carbone, Ignazio (20 January 2017). "The sexual state of". Mycologia. 101 (2): 275–280. doi:10.3852/08-205. JSTOR 20619175. PMID 19397202. S2CID 28375699.
- ^ a b c d Onions, A.H.S.; Allsopp, D.; Eggins, H.O.W. (1981). Smith's introduction to industrial mycology (7th ed.). London, UK: Arnold. ISBN 978-0-7131-2811-6.
- ^ Rodrigues, P.; Santos, C.; Venâncio, A.; Lima, N. (October 2011). "Species identification of Aspergillus section Flavi isolates from Portuguese almonds using phenotypic, including MALDI-TOF ICMS, and molecular approaches". Journal of Applied Microbiology. 111 (4): 877–892. doi:10.1111/j.1365-2672.2011.05116.x. PMID 21790915.
- ^ a b Ramirez-Prado, Jorge H.; Moore, Geromy G.; Horn, Bruce W.; Carbone, Ignazio (September 2008). "Characterization and population analysis of the mating-type genes in Aspergillus flavus and Aspergillus parasiticus". Fungal Genetics and Biology. 45 (9): 1292–1299. doi:10.1016/j.fgb.2008.06.007. PMID 18652906.
- ^ Al-Gabr, H; Ye, C; Zhang, Y; Khan, S; Lin, H; Zheng, T (April 2013). "Effects of carbon, nitrogen and pH on the growth of aspergillum parasiticus and aflatoxins production in water". Journal of Environmental Biology. 34 (2): 353–358. ProQuest 1355249650.
- ^ Corey, JEL; Curtis, GDW; Baird, RM (2003). Aspergillus flavus and parasiticus agar (AFPA). Progress in Industrial Microbiology. Vol. 37. pp. 397–399. doi:10.1016/S0079-6352(03)80029-2. ISBN 9780444510846.
- ^ Bracarense, Adriana A.P.; Takahashi, Jacqueline A. (2014). "Modulation of antimicrobial metabolites production by the fungus Aspergillus parasiticus". Brazilian Journal of Microbiology. 45 (1): 313–321. doi:10.1590/S1517-83822014000100045. PMC 4059316. PMID 24948950.
- ^ Horn, B. W.; Greene, R. L.; Sobolev, V. S.; Dorner, J. W.; Powell, J. H.; Layton, R. C. (1996). "Association of Morphology and Mycotoxin Production with Vegetative Compatibility Groups in Aspergillus flavus, A. parasiticus, and A. tamarii". Mycologia. 88 (4): 574–587. doi:10.2307/3761151. JSTOR 3761151.
- ^ Wee, Josephine; Day, Devin; Linz, John (2 June 2016). "Effects of Zinc Chelators on Aflatoxin Production in Aspergillus parasiticus". Toxins. 8 (6): 171. doi:10.3390/toxins8060171. PMC 4926138. PMID 27271668.
- ^ Guo, Baozhu; Chen, Xiaoping; Dang, Phat; Scully, Brian T; Liang, Xuanqiang; Holbrook, C Corley; Yu, Jiujiang; Culbreath, Albert K (2008). "Peanut gene expression profiling in developing seeds at different reproduction stages during Aspergillus parasiticus infection". BMC Developmental Biology. 8 (1): 12. doi:10.1186/1471-213X-8-12. PMC 2257936. PMID 18248674.
- ^ Zheng, Ajuan; Zhang, Lihui; Wang, Shaojin (May 2017). "Verification of radio frequency pasteurization treatment for controlling Aspergillus parasiticus on corn grains". International Journal of Food Microbiology. 249: 27–34. doi:10.1016/j.ijfoodmicro.2017.02.017. PMID 28271854.
- ^ Pizzolitto, Romina P.; Barberis, Carla L.; Dambolena, José S.; Herrera, Jimena M.; Zunino, María P.; Magnoli, Carina E.; Rubinstein, Héctor R.; Zygadlo, Julio A.; Dalcero, Ana M. (2015). "Inhibitory Effect of Natural Phenolic Compounds on Growth". Journal of Chemistry. 2015: 1–7. doi:10.1155/2015/547925. hdl:11336/15759.
- ^ Tiwari, Shraddha; Gupta, Nupur; Malairaman, Udayabanu; Shankar, Jata (9 September 2017). "Anti-aspergillus Properties of Phytochemicals Against Aflatoxin Producing Aspergillus flavus and Aspergillus parasiticus". National Academy Science Letters. 40 (4): 267–271. doi:10.1007/s40009-017-0569-y. S2CID 256341844.
- ^ Jantapan, K; Poapolathep, A; Imsilp, K; Poapolathep, S; Tanhan, P; Kumagai, S; Jermnak, U (9 June 2016). "Inhibitory Effects of Thai Essential Oils on Potentially Aflatoxigenic Aspergillus parasiticus and Aspergillus flavus". Biocontrol Science. 22 (1): 31–40. doi:10.4265/bio.22.31. PMID 28367868.
- ^ KLICH, MAREN A. (November 2007). "Aspergillus flavus: the major producer of aflatoxin". Molecular Plant Pathology. 8 (6): 713–722. doi:10.1111/j.1364-3703.2007.00436.x. PMID 20507532.